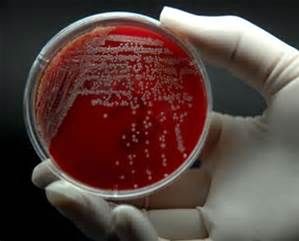
條件致病菌

簡述
大腸桿菌致病條件
(1)寄居部位的改變,如某些大腸桿菌是腸道內的常見菌,當它們進入泌尿道,就會引進泌尿道感染;
(2)機體免疫功能低下,常引起內源性感染;
(3)菌群失調,引起菌群失調症。
條件致病菌又稱為機會致病菌,在某種特定條件下可致病的細菌,稱為條件致病菌。寄居在人體一定部位的細菌,在正常情況下不致病,當機體平衡狀態被破壞時可引起疾病者。
大腸桿菌(1)寄居部位的改變,如某些大腸桿菌是腸道內的常見菌,當它們進入泌尿道,就會引進泌尿道感染;
(2)機體免疫功能低下,常引起內源性感染;
(3)菌群失調,引起菌群失調症。
致病菌(Pathogenic bacteria)能引起疾病的微生物稱為病原微生物或致病菌。病原微生物包括細菌、病毒、螺鏇體、立克次氏體、衣原體、支原體、...
接種 入侵方式 感染 侵害 繁殖正常菌群與宿主之間,正常菌群之間,通過營養競爭,代謝產物的相互制約等因素,維持著良好的生存平衡。在一定條件下這種平衡關係被打破,原來不致病的正常菌群中的...
簡介 致病條件等。常見致病菌有葡萄球菌、鏈球菌、大腸桿菌等。其特點是:同一種致病菌可以引起...等;而不同的致病菌又可引起同一種疾病,如金黃色葡萄球菌、鏈球菌和大腸桿菌都能引起...、氣性壞疽等。它們的致病菌、病程演變和防治方法,都與非特異性感染不同...
特點 分類 病因 化膿性致病菌 發病機制簡介 開展南方重要食源性致病菌分布規律及相關基礎研究,建立南方特色的致病菌種質資源庫,運用分子生物學和生物信 資料 息學手段開展致病菌的分型溯源研究,研究食源性致病菌以信號分子介導的細菌間信息傳播機制,以及探討...
簡介 研究課題 成果專利 獲獎情況 發表文章感染途徑更為少見,甚至於這種感染途徑是否存在,目前也有爭論。二、據致病菌分①非特異性尿道炎,致病菌以大腸埃希桿菌、鏈球菌屬及葡萄球菌屬最常見...),簡稱淋病(gonorrhea),致病菌為淋病奈瑟菌;③非淋病性尿道炎...
簡介 臨床表現 尿道炎危害 分類方法 症狀高技術產品 國家高技術產業化項目生物專項資金項目 常見食源性致病菌分子檢測...食源性致病菌分布規律及相關基礎研究 廣東省自然科學基金研究團隊項目 食源性...動力學研究 廣東省自然科學基金項目 蟲光素酶基因工程菌構建和發酵條件研究...
人物經歷 任免信息 主要成就 社會任職 個人生活高,在性傳播性疾病中占第1位。主要感染途徑:直接蔓延,含有致病菌的尿反流入前列腺導管逆行至腺體,是最常見的感染途徑;血源性感染,致病菌由機體其他...、有利於細菌繁殖的情況,均可誘發急性細菌性前列腺炎,常見致病菌有大腸桿菌...
病症概述 發病原因及發病機制 病因病理 臨床表現 檢查診斷一些條件致病菌如表皮葡萄球菌白色葡萄球菌、蠟樣芽孢桿菌等逐漸占據顯著地位...為3天左右。表皮葡萄球菌、白色葡萄球菌等條件致病菌、使用抗生素治療以及...。 病因 葡萄球菌化膿性眼內炎的致病菌主要為細菌和真菌,以細菌更為常見以往...
流行病學 病因 臨床表現 診斷 檢查